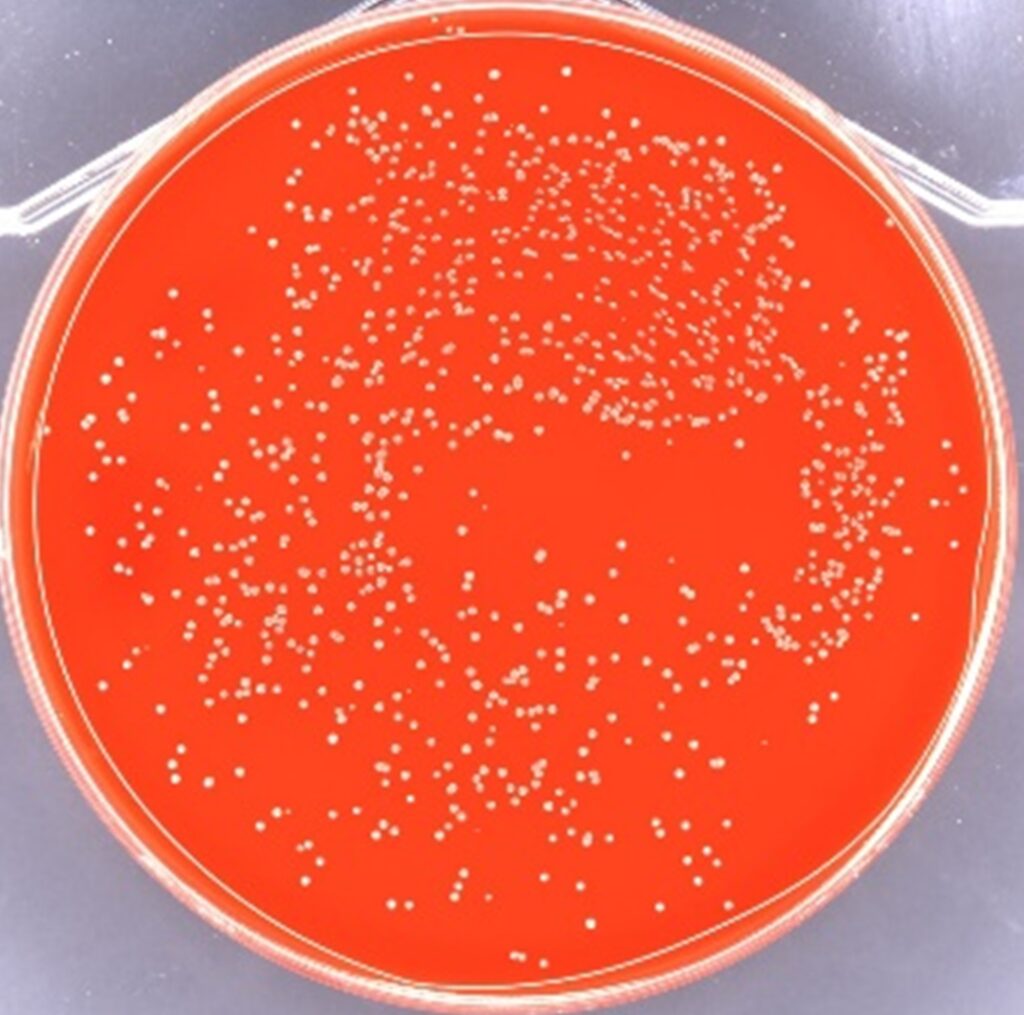

お知らせ
百日咳菌の抗菌性試験 受注開始
- 感染症の流行を背景に、試験ニーズに迅速対応 -
2026/03/02
一般財団法人ニッセンケン品質評価センター(以下 ニッセンケン、理事長:安藤 健)は、2026年3月より百日咳菌(Bordetella pertussis)を用いた抗菌性試験の受注を開始いたします。
ニッセンケンでは、2025年8月に肺炎マイコプラズマ試験の対応を開始していますが、同年に百日咳の患者数が過去最多を記録※したことを受け、このたび新たに百日咳菌を対象とした試験体制をいち早く導入しました。感染症への関心が再び高まる中、衛生関連製品や機能性素材における科学的根拠に基づく安全性・有効性評価の重要性も 増しています。ニッセンケンはこうしたニーズに的確に対応できる体制を整えています。
※2025年の感染症発生動向調査によると、百日咳の累積報告数は約9万件に達し、前年の年間報告数と比べて20倍以上となっています。(データ出典:国立健康危機管理研究機構 感染症発生動向調査週報〈IDWR〉 2024年第52週、2025年第52週)
百日咳菌とは
百日咳菌は細菌の一種であり、咳やくしゃみによる飛沫感染を介して広がる呼吸器 感染症の原因菌です。特に乳児期早期では重篤になりやすいため注意が必要とされています。乳児期にワクチンの定期接種が実施されている一方、免疫は時間とともに低下するとされ、青年・成人でも感染が確認されるケースが報告されています。
こうした背景を受け、製品開発段階においても、百日咳菌に対する抗菌性能を科学的に検証し、客観的なエビデンスを備える重要性が高まっています。
Bordetella pertussis
(血液寒天培地上コロニーの様子)
試験概要
本試験は製品の品質評価を目的として、技術説明や研究資料等でご活用いただけます。ただし、薬機法に基づく 表示には医療機器としての認可が別途必要です。
| 目的 | 百日咳菌の減少効果を評価 |
| 試験菌種 | 百日咳菌 Bordetella pertussis NBRC 107857 |
| 試験対象の例 | ハンカチ、タオル、マスクなどの繊維製品 |
| 試験方法 | JIS L 1922準用 |
| 検体必要量 | 5 g以上 |
※なお、評価目的に応じた条件設定によるアレンジ試験のご相談にも対応しております。
本リリースに関するお問い合わせ先
一般財団法人ニッセンケン品質評価センター ライフ アンド ヘルス事業本部 バイオケミカルグループ
> ニッセンケン事業拠点 > お問い合わせフォーム
各種お問い合わせCONTACT
サービス全般についてのお問い合わせ
![]()
各種試験・検査に関するお問い合わせ、ご依頼はこちらから承ります。
エコテックス®に対するお問い合わせ
![]()
エコテックス®認証に関するお問い合わせ、ご依頼はこちらから承ります。
技術資料ダウンロード
![]()
各種試験・検査に関する技術資料が、こちらからダウンロードいただけます。
よくあるご質問
![]()
試験・検査などで、皆さまからよくいただく質問と回答をまとめています。
お電話からのお問い合わせはこちら
